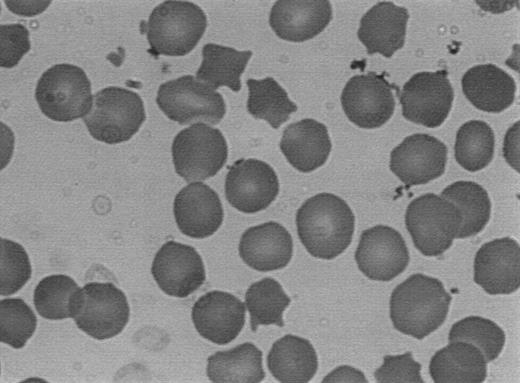
Fig. 5. Typical peripheral blood smear of patients with mutations of the β-spectrin gene. Note the conspicuous spherocytosis and the presence of frequent dense spiculated cells (acanthocytes).

Abstract
Several subsets of patients with hereditary spherocytosis (HS) have been defined based on the specific red blood cell membrane protein deficiencies involving spectrin, ankyrin, band 3, and protein 4.2. Mutations of the genes encoding these proteins are currently being uncovered. Regarding spectrin, only three isolated cases of β-spectrin gene mutations were recently reported in association with HS and spectrin deficiency. We have screened the coding region of the β-spectrin gene using the SSCP technique, in 40 families with HS associated with spectrin deficiency or combined spectrin and ankyrin deficiencies. In this report we describe six frameshift and nonsense mutations and four missense mutations of the β-spectrin gene in 11 unrelated families. Taking advantage of modifications in the restriction enzyme recognition sequences introduced by the mutations, we show, in all cases of frameshift and nonsense mutations, the loss of heterozygosity at the cDNA level when compared to genomic DNA, reflecting the absence of the mutant mRNA transcripts. In one family with a large pedigree including six generations and 112 members, we firmly establish the autosomal dominant inheritance of one of the β-spectrin null mutations. Most of the mutations described are responsible for a phenotype of mild to moderate autosomal dominant form of HS associated with a conspicuous spherocytosis with frequent spiculated cells (8% to 15% acanthocytes). One missense mutation appears to be associated with a recessive form of the disease. Five common restriction enzyme polymorphisms of the coding region of the β-spectrin gene are also described. Overall, these findings underscore the importance of the β-spectrin gene mutations in the pathogenesis of HS and reemphasizes the extreme heterogeneity of the underlying molecular basis of this condition.
HEREDITARY SPHEROCYTOSIS (HS) comprises a heterogeneous group of hemolytic anemias characterized by a chronic hemolysis with a broad spectrum of clinical severity ranging from asymptomatic to severe anemia requiring splenectomy, a distinctive red blood cell (RBC) morphology reflecting a varying degree of surface area deficiency resulting in a spherocytic phenotype and increased osmotic fragility, and an autosomal dominant or, less often, autosomal recessive pattern of inheritance.1 It is now well established that hereditary spherocytosis is the consequence of heterogeneous defects affecting the proteins of the RBC membrane.
The lipid bilayer that constitutes this membrane is supported by the RBC skeleton, a protein lattice that laminates the inner side of the RBC membrane, and which is partly responsible for the shape and deformability of the RBC.2,3 Spectrin, its major constituent, comprises two subunits α and β, intertwined in an antiparallel direction to form heterodimers.4,5 By binding at their head region, spectrin heterodimers are assembled into tetramers, which are interconnected into a two-dimensional network by their linkage to oligomers of actin at their distal ends.6-8 This mesh of hexagonal structures, which ensures the support of the overlaying membrane, is attached to the lipid bilayer mainly via ankyrin, which binds to spectrin on the one hand9-11 and to the transmembrane anion transporter band 3 on the other.10 12 This binding is strengthened by other interactions including protein 4.2-band 3, protein 4.1-glycophorin C, and weak interactions of spectrin and protein 4.1 with the negatively charged lipids of the inner half of the bilayer. The weakening of these so-called vertical protein interactions (as opposed to the horizontal protein interactions consisting of spectrin dimer-spectrin dimer binding and spectrin-protein 4.1-actin binding), which ensure the anchoring of the skeleton to the lipid bilayer, may play an essential role in the pathogenesis of HS.
Indeed, the analysis of the RBC membrane proteins by sodium dodecyl sulfate-polyacrylamide gel electrophoresis (SDS-PAGE) or radioimmunoassay enables one to recognize several alternative protein deficiencies defining four distinct subsets of HS patients: patients with (1) isolated spectrin deficiency,13,14 (2) combined spectrin and ankyrin deficiency,15-17 (3) band 3 deficiency,18-21 or (4) protein 4.2 deficiency.22-26 Several mutations of band 3,27-32 ankyrin,33-36 and protein 4.237-41 have been reported in patients with band 3, ankyrin, or protein 4.2 deficiency, respectively. More recently, three isolated β-spectrin mutations associated with HS have been uncovered and their consequences characterized: the first involved a point mutation occurring in the N-terminal region of β-spectrin leading to a defective binding of spectrin to protein 4.1.42,43 A truncated β-spectrin due to a large genomic deletion including exons 22 and 23 has also been reported,44 and a third mutation of β-spectrin characterized by a truncated β-chain lacking exons 16 and 17 and associated with hereditary spherocytosis and overall spectrin deficiency has also been extensively studied.45
Using the single-stranded conformation polymorphism (SSCP) technique, we have undertaken to screen the coding region of the β-spectrin gene in 40 families with hereditary spherocytosis associated with spectrin deficiency (including seven families with concomitant ankyrin deficiency). We report here on the results of this work which has enabled us to uncover several frameshift, nonsense, and missense mutations affecting that gene. We were also able to convincingly establish a statistically significant linkage between a null mutation of the β-spectrin gene and the HS phenotype in one very large pedigree, thereby firmly establishing the autosomal dominant inheritance of the β-spectrin null mutations.
MATERIALS AND METHODS
Subjects.We have studied 40 families from the United States and Europe with a diagnosis of typical hereditary spherocytosis based on a history of hereditary hemolytic anemia, associated with a characteristic spherocytic phenotype of the RBCs, and an increased osmotic fragility, as well as exclusion of other known causes of spherocytic hemolytic anemias. These families were selected from a larger and more heterogeneous pool of patients with HS referred to our laboratory based on the characteristic feature of spectrin deficiency as assessed by SDS-PAGE analysis of the RBC membrane proteins described below, as well as availability of genomic DNA. These patients include individuals with associated ankyrin deficiency (7 of 40 families). In our experience, the patients with spectrin deficiency and those with combined spectrin and ankyrin deficiencies as assessed by SDS-PAGE analysis of the RBC membrane proteins represent 41% and 19% of the total population of HS patients, respectively. However, it should be emphasized that SDS-PAGE analysis of the RBC membrane proteins described below is an insensitive method for the detection of ankyrin deficiency on the membrane. Therefore, the number of patients with combined spectrin and ankyrin deficiency in the population concerned by this report, as well as in our overall population of patients with HS, may have been underestimated.
Analysis of the erythrocyte membrane proteins.Fresh blood was collected from the patients and control individuals on acid citrate/dextrose, shipped on ice to our laboratory, and analyzed within 48 hours of collection. The methods used have been described previously and include (1) erythrocyte membrane preparation46; and (2) analysis of the erythrocyte membrane proteins by SDS-PAGE (3.5% to 17% gradient Fairbanks gels and 10% Laemmli polyacrylamide gels),47 followed by densitometric analysis of the Coomassie blue stained gels and quantitation of the individual proteins relative to band 3.
Screening of the spectrin gene by polymerase chain reaction (PCR)-SSCP.Genomic DNA was prepared from peripheral blood mononuclear cells isolated from each individual patient and control samples, as described previously.48 Each coding exon of the β-spectrin gene was amplified by the PCR using genomic DNA from each individual as template and primers flanking the individual exons and overlapping the intron-exon boundaries49 (primers and conditions available from the authors upon request). Six hundred nucleotides out of the 6,414 nucleotides of the coding region are included in the primer sequences and were therefore not examined by this study. Forty nucleotides of the 5′ untranslated region directly upstream of the initiation codon, and 45 nucleotides of the 3′ untranslated region directly downstream of the termination codon were also analyzed by this study. 2.5 μCi[32P] dATP (3,000 μCi/mmol; ICN Biomedicals, Inc, Costa Mesa, CA) was added to each 10-μL PCR reaction. The PCR products were then analyzed by SSCP as described previously, with minor modifications.50 51 In brief, 2 μL of the PCR product was diluted in 30 to 50 μL of formamide loading buffer (86% formamide, 20 mmol/L EDTA, 0.25% bromophenol blue, 0.25% xylene cyanol, and optional 10% glycerol). The mixture was heated to 95°C for 5 minutes to completely denature the DNA, then rapidly chilled on ice for 10 minutes. An aliquot of the sample (5 μL) was then subjected to electrophoresis at 8 W, for 16 hours, at room temperature in a nondenaturing polyacrylamide gel prepared according to the manufacturer's specifications (MDE gel; AT Biochem, Malvern, PA). After completion of the electrophoresis, the gel was exposed to Kodak XAR-5 film (Eastman Kodak, Rochester, NY) overnight at −80°C. Each gel enabled us to examine simultaneously a single exon amplified from 40 individual samples. Abnormally migrating bands were further characterized by sequencing.
Direct sequencing of amplified DNA.DNA fragments generated by PCR amplification were purified using the Geneclean system (BIO 101, Natick, MA) and sequenced using the Sequenase kit, version 2.0 (USB, Cleveland, OH) as recommended by the manufacturer with the following minor modification: the initial alkaline denaturation of the template is replaced by simple heat denaturation in the presence of the sequencing primer (95°C for 5 minutes), followed by quick chilling on ice for 10 minutes. The primers used for the PCR amplification were also used for direct sequencing.
Subcloning and sequencing of amplified DNA.DNA fragments generated by PCR amplification were purified using the Geneclean system (BIO 101) and subcloned into the pCRII cloning vector (Invitrogen Corp, San Diego, CA). After transformation in competent Escherichia coli cells, the recombinant DNA clones were sequenced by the dideoxynucleotide sequencing method of Sanger et al.52
Restriction enzyme analysis of genomic and cDNA.To address the stability of the mutant mRNA, we took advantage of the abrogation or creation of restriction sites by the point mutations. Genomic DNA was prepared from peripheral blood mononuclear cells as described previously.48 Total RNA isolated from reticulocytes53 was reverse transcribed using random primers. Individual exons of interest were amplified by PCR using genomic DNA and cDNA alternatively as template. The resulting products were digested with the appropriate restriction enzyme. The heterozygous genomic DNA pattern of digestion was compared with the pattern displayed using cDNA to reflect on the presence or absence of expressed mRNA transcript. In the single case where no restriction site change was introduced by the mutation, we took advantage of the known Sac I polymorphism of the β-spectrin gene and again compared the heterozygous pattern of genomic digestion with that obtained using cDNA.
Statistical analysis.The statistical analysis was performed on the data obtained from one large pedigree (including six generations and 112 members) with HS and a β-spectrin frameshift mutation. Blood samples from 47 members of the family at genetic risk (including 15 patients and 32 healthy members) were available for analysis. Hemoglobin levels, percentage of reticulocytes, and genomic DNA sequence were determined. The maximum lod score is calculated with the computer program VITESSE.54 A large maximum lod score, especially one exceeding the traditional cutoff of 3.0, suggests that the genetic locus under consideration is linked to the disease locus. Furthermore, the level of recombination that maximizes the lod score estimates the genetic distance between the two loci. Thus, if the frameshift is indeed responsible for the spherocytic phenotype, in this family, the maximum lod score should be large and should occur at a recombination fraction of 0.00.
RESULTS
A subset of patients with HS and spectrin deficiency have heterogeneous frameshift and nonsense mutations of the spectrin gene.Among the large pool of patients with HS referred to our laboratory, we have selected the subset of patients whose RBC skeleton displayed a deficiency in spectrin as assessed by SDS-PAGE analysis of the membrane proteins. A total of 72 samples belonging to 40 families were analyzed alongside control samples (7 of 40 families showed a concomitant ankyrin deficiency). The 31 coding exons of the β-spectrin gene as well as small segments of the 3′ untranslated and 5′ untranslated regions were examined by the SSCP technique as described in Materials and Methods. Several patients' samples displayed a unique abnormal migration of specific exons (Fig 1). These exons of interest were reamplified by PCR using genomic DNA from the corresponding appropriate patient, and sequenced by direct sequencing. Six of them revealed frameshift or nonsense mutations in various exons (Fig 2) and have been designated as follows according to a recently suggested nomenclature for designation of mutations55 (the numbering of the nucleotides is in accordance with the one previously published56 ): Sp Tabor or Q1946X: nonsense mutation at codon 1946, exon 28, CAG → TAG; Sp Baltimore or Q845X: nonsense mutation at codon 845, exon 14, CAG → TAG; Sp Ostrava or 699delT: frameshift mutation at nucleotide 699, exon 6, T deletion, premature termination after addition of nine AA; Sp Philadelphia or 1862insA: frameshift mutation at nucleotide 1862, exon 13, A insertion, premature termination after addition of 14 AA; Sp Bergen or 2441insA: frameshift mutation at nucleotide 2441, exon 14, A insertion, premature termination after the addition of 14 AA; Sp Houston or 2872delA: frameshift mutation at nucleotide 2872, exon 15, A deletion, premature termination after addition of six AA. This last mutation was found in two apparently unrelated patients.
Analysis of gDNA by SSCP. Genomic DNA was isolated from the peripheral blood mononuclear cells of patients and control subjects. The PCR was used to amplify individual exons of the β-spectrin gene for further analysis by SSCP. Shown are selected SSCP films pertaining to the exons of interest from the six patients who were ultimately found to have frameshift and nonsense mutations of the β-spectrin gene. Note the abnormal migration of additional bands in the patients (arrows), suggesting the presence of a mutation within one of the two alleles.
Analysis of gDNA by SSCP. Genomic DNA was isolated from the peripheral blood mononuclear cells of patients and control subjects. The PCR was used to amplify individual exons of the β-spectrin gene for further analysis by SSCP. Shown are selected SSCP films pertaining to the exons of interest from the six patients who were ultimately found to have frameshift and nonsense mutations of the β-spectrin gene. Note the abnormal migration of additional bands in the patients (arrows), suggesting the presence of a mutation within one of the two alleles.
Characterization of the β-spectrin mutations. Using the SSCP primers, and genomic DNA prepared from the patients' peripheral blood mononuclear cells, individual exons of interest were reamplified. The resulting DNA fragments were sequenced either by direct sequencing or by subcloning and sequencing of individual clones. Shown are the six frameshift and nonsense mutations of the β-spectrin gene. Note the base substitution in the cases of Sp Tabor and Sp Baltimore (nonsense mutations) reflected by the observation of two bands present at the same level by direct sequencing, as well as the base deletion or insertion (frameshift mutations) in the four other mutants seen by sequencing of individual clones.
Characterization of the β-spectrin mutations. Using the SSCP primers, and genomic DNA prepared from the patients' peripheral blood mononuclear cells, individual exons of interest were reamplified. The resulting DNA fragments were sequenced either by direct sequencing or by subcloning and sequencing of individual clones. Shown are the six frameshift and nonsense mutations of the β-spectrin gene. Note the base substitution in the cases of Sp Tabor and Sp Baltimore (nonsense mutations) reflected by the observation of two bands present at the same level by direct sequencing, as well as the base deletion or insertion (frameshift mutations) in the four other mutants seen by sequencing of individual clones.
The frameshift and nonsense mutations result in the silencing of the mutant allele (ie, null mutations).To assess the consequence of these frameshift and nonsense mutations on the mutant mRNA we took advantage of the restriction site modifications introduced by the nucleotide sequence alteration. With the exclusion of spectrin Houston, all the mutations described result in the modification of the restriction map. As described in Materials and Methods, we compared the heterozygous pattern of restriction digest introduced by the mutation in the genomic DNA with that attained using cDNA. As shown in Fig 3, the loss of heterozygosity at the cDNA level reflects the absence of the mutant transcript within the reticulocyte mRNA. This observation may be the result of an unstable mutant transcript, or other poorly elucidated mechanism. In the case of spectrin Houston where the mutation did not result in alteration of the restriction map, we took advantage of the Sac I polymorphism of the β-spectrin gene for which the specific patient happened to be heterozygous. Much like the other mutations described, the loss of heterozygosity for the Sac I polymorphism at the cDNA level also reflects the absence of the mutant transcript in reticulocytes. We conclude that these frameshift and nonsense mutations result in the silencing of the mutant β-spectrin allele (ie, null mutations).
Instability of the mutant mRNA. To address the stability of the mutant mRNA, we took advantage of the abrogation or creation of restriction sites by the point mutations. In this example (Sp Ostrava or 699delT), we took advantage of the PvuII restriction site abrogated by the mutation. Note the contrast between the heterozygous pattern of the genomic DNA and the homozygous pattern of the cDNA for the PvuII site in the patient's sample, suggesting the absence of one of the two transcriptional messages.
Instability of the mutant mRNA. To address the stability of the mutant mRNA, we took advantage of the abrogation or creation of restriction sites by the point mutations. In this example (Sp Ostrava or 699delT), we took advantage of the PvuII restriction site abrogated by the mutation. Note the contrast between the heterozygous pattern of the genomic DNA and the homozygous pattern of the cDNA for the PvuII site in the patient's sample, suggesting the absence of one of the two transcriptional messages.
Null mutations of the β-spectrin gene are associated with a typical form of autosomal dominant HS of mild to moderate severity with a conspicuous spherocytosis and frequent spiculated RBCs.The six frameshift or nonsense mutations of the β-spectrin gene were shown to result in complete silencing of the mutated allele (ie, null mutation). The four families in which at least three successive generations were available for clinical evaluation (and in some cases biochemical analysis) exhibited a typical pattern of autosomal dominant disease. More importantly, in one large pedigree with HS including six generations and 112 members (shown in Fig 4), a frameshift mutation (spectrin Bergen or 2441insA) was uncovered and found to be present in the heterozygous state in all 15 affected members and none of the 32 healthy family members at genetic risk tested. Using the computer program VITESSE, the maximum lod score associated with this pedigree is 5.67, largely exceeding the traditional cutoff of 3.0. This result is strongly significant (P < .0001) and occurs at a recombination fraction of 0.00, providing strong statistical evidence that the spherocytosis in this family is caused by the frameshift mutation. Furthermore, these observations strongly support the concept that the silencing of one β-spectrin allele results in expression of the HS phenotype.
Pedigree of the family showing a statistically significant linkage between HS and a β-spectrin frameshift mutation (β-spectrin Bergen or 2441insA): (•), HS patients; (○), healthy members; hematologic data as well as sequence of the β-spectrin gene were available on 15 of 23 affected patients and 32 healthy individuals at genetic risk within the family: β, normal β-spectrin allele: β0, β-spectrin Bergen. Only 2 of the 23 patients have not been splenectomized (these are III-7 and IV-16). The latter is awaiting splenectomy.
Pedigree of the family showing a statistically significant linkage between HS and a β-spectrin frameshift mutation (β-spectrin Bergen or 2441insA): (•), HS patients; (○), healthy members; hematologic data as well as sequence of the β-spectrin gene were available on 15 of 23 affected patients and 32 healthy individuals at genetic risk within the family: β, normal β-spectrin allele: β0, β-spectrin Bergen. Only 2 of the 23 patients have not been splenectomized (these are III-7 and IV-16). The latter is awaiting splenectomy.
In these null mutations, the observed clinical ailment consists in a mild to moderate form of typical HS (using the severity index previously published13 ). The hemoglobin level ranges from 9 g/dL to 13.5 g/dL, and the reticulocyte count ranges from 5.4% to 18%. A history of cholecystectomy is present in 3 of the 6 index patients and in 6 of 6 families. A history of splenectomy is also present in 3 of 6 index patients and in 6 of 6 families. Examination of the peripheral blood smear shows a fairly uniform pattern among different families, displaying a conspicuous spherocytosis with frequently encountered dense spiculated RBCs (acanthocytes) varying in percentage from 8% to 15% (Fig 5). The biochemical analysis of the RBC membrane proteins shows a moderate deficiency in the overall spectrin content of the RBCs ranging from 21% to 30% (Table 1).
Typical peripheral blood smear of patients with mutations of the β-spectrin gene. Note the conspicuous spherocytosis and the presence of frequent dense spiculated cells (acanthocytes).
Typical peripheral blood smear of patients with mutations of the β-spectrin gene. Note the conspicuous spherocytosis and the presence of frequent dense spiculated cells (acanthocytes).
The large 112-member and six-generation pedigree was ideally suited for analysis of the β-spectrin null mutations. Within this family the phenotype of the disease varied from mild to moderate severity, the hematocrit ranging from 9 g/dL to 13.5 g/dL, and the reticulocyte count ranging from 5% to 14%. Splenectomy had been indicated in 21 of 23 affected family members. Genomic DNA sequencing showed that all of the 15 affected members and none of the 32 healthy members at genetic risk tested carried the mutation, confirming that a null mutation of the spectrin gene is associated with at least a mild form of the disease.
The limited clinical variability between the families with null mutations, as well as between various members within a single family is not well understood, but has also been reported in ankyrin null mutations, and is probably related to yet unidentified factors that modulate the expression of the phenotype.
Some patients with HS and spectrin deficiency present unique missense mutations of the β-spectrin gene.Among the patients' genomic DNA samples analyzed, four exhibited a missense mutation of specific exons of the β-spectrin gene. These missense mutations have been designated according to the recently suggested nomenclature for designation of mutations55 and include spectrin Atlanta or W182G: tryptophan to glycine substitution at codon 182 in exon 5; spectrin Birmingham or R1684C: arginine to cysteine substitution at codon 1684 in exon 25; spectrin Oakland or I220V: isoleucine to valine substitution at codon 220, in exon 7; and spectrin Columbus or P1227S: proline to serine substitution at codon 1227 in exon 17, respectively, for the four patients. Although the significance of these amino acid substitutions remains uncertain, They were not detected in 222 other samples tested, and therefore are unlikely to represent simple polymorphisms. It is likely that these amino acids play a crucial functional role. This is highly probable in the case of the W182G mutation because this residue, which is located in close proximity of the actin binding domain, is strictly conserved among all actin-binding proteins,57 which suggests a critical role in the actin binding property of β-spectrin.
Sufficient clinical data were available on three out of the four families and indicates a more heterogeneous group of patients. Two families present a clinical picture consistent with an autosomal dominant HS of mild and moderate severity, respectively (hemoglobin 10 and 13 g/dL, reticulocyte count 10% and 5%, respectively, both index patients having required splenectomy). The third family showed a recessive pattern with both parents being completely asymptomatic, although both displayed a low normal hematocrit and a minimal elevation of the reticulocyte count. The child had a severe form of the disease, requiring periodic transfusions with a hemoglobin as low as 7 g/dL. We could not detect in this patient another mutation presumably carried by the other β-spectrin allele. Peripheral blood smears were available on the two patients with an autosomal dominant disease and showed the same conspicuous spherocytosis with frequent acanthocytes.
Several polymorphisms are encountered in the coding region of the β-spectrin gene.Screening of the β-spectrin gene by SSCP has uncovered five polymorphisms within the coding region of the gene. These polymorphisms modify the restriction map of the gene and can therefore be conveniently identified using restriction enzyme analysis. They have been designated according to the suggested nomenclature55 and include: Sac I polymorphism or 5630C → T: C to T substitution at nucleotide 5630 in exon 26, with no amino acid change; NlaIII polymorphism or 503C → T: C to T substitution at nucleotide 503 in exon 4, with no amino acid change; Dde I polymorphism or N439S: A to G substitution at nucleotide 1411 in exon 11, leading to asparagine to serine substitution at codon 439; SfaNI polymorphism or 2249C → A: C to A substitution at nucleotide 2249 in exon 14, with no amino acid change; and SfaNI polymorphism or D1151N: G to A substitution at nucleotide 3546 in exon 16, leading to aspartic acid to asparagine substitution at codon 1151. Based on the analysis of the 222 samples (including patients and control samples), the prevalence of these polymorphisms in the general population has been estimated and is presented in Table 2.
DISCUSSION
It is now well established that analysis of the RBC membrane proteins can identify several subsets of patients with HS characterized by isolated or combined protein deficiencies. In recent years, mutations involving the genes of ankyrin,33-36 band 3,27-32 protein 4.2,37-41 and spectrin43,44,58 have been uncovered in association with the HS phenotype. In the case of β-spectrin, only three mutant proteins in association with HS have been previously studied. The first one involved a point mutation occurring in the N-terminal region of β-spectrin, leading to a defective binding to protein 4.1, and accounting for an unstable protein as suggested by expression studies of the mutated peptide in E coli.43 59 Another mutant β-spectrin missing most of repeated segment 12 and part of repeated segment 13 due to a large genomic deletion was shown, based on binding assays of synthetic peptides, to exhibit an abnormal binding to ankyrin.44 This dysfunction is attributed to conformational changes affecting the ankyrin binding domain located within the 15th repeated segment, in the vicinity of the deletion. A third mutant β-spectrin involving the skipping of exons 16 and 17 was shown to result in a partially unstable mRNA and possibly unstable protein.45 In this report we show that the heterogeneity that has been the hallmark of the ankyrin and band 3 mutations in HS also characterizes the β-spectrin mutations. Indeed, the mutations described in this report are widespread throughout the β-spectrin gene, and result (at least in the case of frameshift and nonsense mutations) in the generation of an undetectable transcriptional message.
Therefore, it appears that, in HS, the mutations affecting the skeletal proteins including spectrin, ankyrin, band 3, and protein 4.2, are very heterogeneous, widely distributed throughout the affected genes, and include frameshift, nonsense, or missense mutations, consensus splice site mutations, and large genomic deletions. Such molecular defects have been shown to alter the stability of the transcriptional message, or the stability of the protein, or to lead to the disruption of specific functions of the protein in yet other instances. Much like mutations of the globin gene in thalassemia, the net result may be a total silencing of one allele (ie, null mutation), a partial disabling of one gene with reduced expression of a normal protein as described in some ankyrin mutations,33 or production of a dysfunctional peptide.44 These adverse effects ultimately result in the deficiency of the affected protein. Despite this apparent heterogeneity of the underlying molecular defects of HS, the disruption of the vertical protein interactions that sustain the tight association of the membrane with its underlying skeleton appears to be the common denominator of such diverse mutations. The disruption of this vertical association, via the weakening of one of its components which include spectrin-ankyrin, ankyrin-band 3, band 3-protein 4.2, and glycophorin C-protein 4.1, is proposed as the basis for the uncoupling of the membrane from its supportive skeleton, resulting in the shedding of membrane vesicles and surface area deficiency in HS. It has been suggested that this latter event may occur via the loss of the lipid anchoring function of band 3. Indeed, because the lateral mobility of band 3 is inversely related to the spectrin concentration, patients with spectrin deficiency may have hypermobile band 3, which could lead to an increased probability that areas of the lipid bilayer would become transiently depleted of band 3 and prone to shedding by exocytosis.60
Expression of the HS phenotype in heterozygous mutations of the β-spectrin gene, which results in an autosomal dominant pattern of inheritance, has been postulated in the three previously described spectrin mutations. Furthermore, several lines of evidence predicate the importance of the regulatory role played by the β-spectrin subunit in the heterodimer assembly onto the membrane, and therefore support an autosomal-dominant transmission hypothesis of β-spectrin mutations. Indeed, pulse-labeling studies in cultured erythroid cell lines from chicken and mammalian erythroblasts have established that the amount of a spectrin synthesized exceeds by threefold the amount of β-subunits synthesized.61-64 Furthermore, the rate of cytoplasmic degradation of the β-subunit significantly outpaces the slower lysosomal degradation pathway of its α subunit counterpart.65 The rate of turnover of the β-spectrin subunit is therefore viewed as critical to the posttranscriptional regulation of the spectrin heterodimer assembly onto the membrane.64 65 In this report we find a clear autosomal dominant pattern of transmission in all the available families (four of the six families) with a null β-spectrin mutation. More importantly, we find a statistically significant linkage between a null β-spectrin mutation (spectrin Bergen) and the HS phenotype in one large pedigree including six generations and 112 members. These findings provide convincing evidence that, like most ankyrin and band 3 mutations, null mutations of the β-spectrin gene are indeed expressed in the heterozygous state, and bring credibility to the model lending a pivotal role to the β-spectrin subunit in the regulation of spectrin heterodimer assembly onto the membrane. Much like some ankyrin mutations, it is possible that other β-spectrin mutations leading to the reduced expression of a normal protein, or leading to the production of a dysfunctional protein, may have less dramatic consequences and may exhibit a recessive pattern of inheritance. This is probably the case for the missense mutation described in this report and which appears to be associated with a recessive form of the disease (spectrin Birmingham or R1684C).
It is interesting to note that the phenotype in the families presenting a null β-spectrin mutation is fairly homogeneous regardless of the underlying molecular defect. This finding is not unexpected because these mutations result ultimately in the same complete silencing of one β-spectrin allele. The limited variability of the phenotype (mild to moderate severity) noted between these null mutations of the β-spectrin gene, as well as between affected members within a single family, remains unexplained and may suggest a role for yet unidentified factors that modulate the expression of the phenotype.
The finding of a conspicuous spherocytosis associated with frequent spiculated cells appears to be a feature common to all these β-spectrin mutations; however, its mechanism and significance remain unclear at the present time. It is interesting to note that the finding of acanthocytes has been previously noted in splenectomized patients with HS,66 and more specifically, has been recognized in the initial,43 as well as in the two subsequent isolated reports of β-spectrin mutations associated with HS.44 45 In our experience, this feature is present even in unsplenectomized patients.
In summary, we have described several frameshift, nonsense, and missense mutations of the β-spectrin gene in the subset of patients with hereditary spherocytosis and spectrin deficiency. We have shown that most of these mutations are associated with a phenotype of mild to moderate autosomal dominant form of the disease associated with a conspicuous spherocytosis with frequent spiculated cells (acanthocytes). As expected, our data also suggest that recessive mutations of the β-spectrin gene may also be encountered, as is the case for ankyrin mutations. These observations reemphasize the heterogeneity of the underlying molecular defect in HS and bring support to the proposed unifying model ascribing the pathogenesis of HS to the weakening of the vertical protein interactions on the RBC membrane.
ACKNOWLEDGMENT
We are indebted to Donna Marie Mironchuk for preparing the photographic illustrations and Diana Fraser for expert secretarial assistance.
Supported by National Institutes of Health Grants No. K08 HL02720 (to H.H.) and HL37462 and HL27215 (to J.P.). P.R.N. is supported by the E. Dethloff Stoltz, A. Riisoen, and E. Riisoen Fund.
Address reprint requests to H. Hassoun, MD, Division of Hematology/Oncology, St Elizabeth's Medical Center, 736 Cambridge St, Boston, MA 02135.